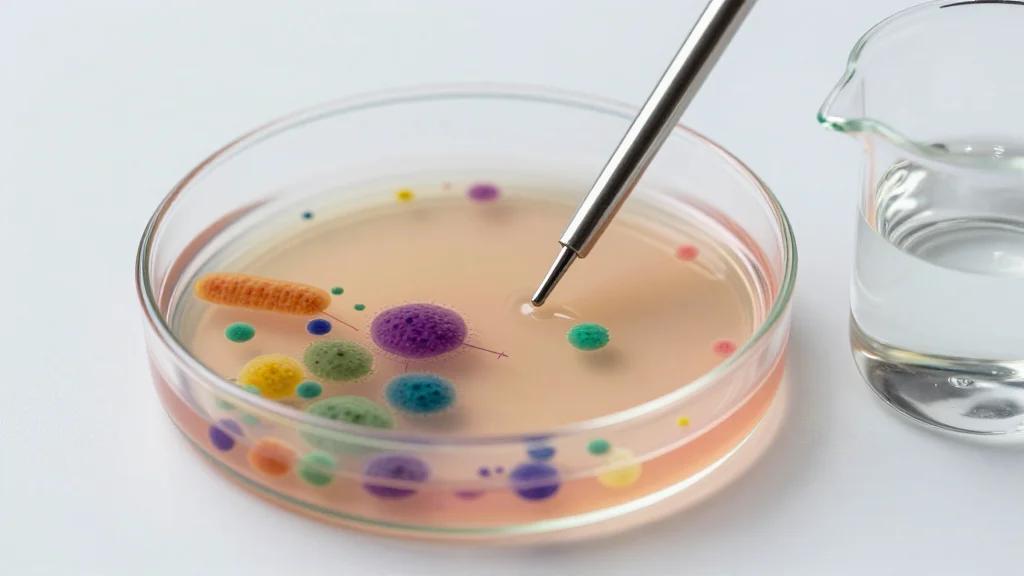
Antibiotic Resistance Can Vary Depending on Where the Bacteria Live

Position Green Launches Decarbonization Investment ROI Calculator
Position Green, a sustainability software and advisory firm, unveiled an ROI Calculator that translates decarbonization projects into quantifiable financial metrics. Developed using a model from Stockholm School of Economics professor Rickard Sandberg, the tool provides ROI, NPV, payback period, emissions impact, and carbon‑tax savings based on user‑defined assumptions. The interactive platform lets companies model multiple scenarios instantly, helping finance and sustainability teams build stronger business cases. CEO Daniel Gadd said the calculator bridges the language gap between environmental goals and financial decision‑making.

Johns Hopkins Leads $24M Multinational Consortium to Find Hepatitis B Cure
Johns Hopkins Medicine is heading a five‑year, $24 million NIH‑funded Hepatitis B and HIV Cure Consortium that brings together research teams from the United States, Brazil, India, Senegal and Uganda. The first year will enroll 450 participants co‑infected with HIV and chronic...

Fujifilm Highlights AI-Driven Products That Help Enhance Enterprise Imaging Workflows
Fujifilm Healthcare Americas showcased its AI‑driven Synapse enterprise imaging portfolio at HIMSS 2026 in Las Vegas. The lineup highlighted the Synapse AI Orchestrator, which embeds diverse AI algorithms into PACS workflows, and the Synapse Worklist Orchestrator, which uses AI learning...

FortiGate Devices Exploited to Breach Networks and Steal Service Account Credentials
Threat actors are exploiting FortiGate next‑generation firewalls to gain initial access and harvest service‑account credentials. Researchers identified abuse of recent CVEs (2025‑59718, 2025‑59719, 2026‑24858) and misconfigurations to extract configuration files containing LDAP and AD service accounts, targeting healthcare, government and...

Roboticom Announces New Distribution and Innovation Partnership with Forged Path Automation
Roboticom announced a distribution and innovation partnership with Forged Path Automation to broaden U.S. market reach and develop turnkey process‑automation solutions. The deal leverages Roboticom’s ARPP® software, which reduces robot training from weeks to days, and its SandRob™ finishing robot...

Want to Work with Athletes and Entertainers? Here's How AI Can Help You Get in the Game
A new Gregory report shows financial advisors can win athlete and entertainer clients by optimizing AI search visibility. The study analyzed 20,771 AI responses and found firms with dedicated persona pages received the most citations, with Creative Planning’s athlete page...

COPV Damage Tolerance Life Demonstration Guidelines
NASA's NESC released new guidelines for damage‑tolerance life demonstration of composite overwrapped pressure vessels (COPVs). The guidance aligns with AIAA S‑081 and NASA‑STD‑5019, applying a four‑times life factor to ensure detectable cracks remain subcritical throughout service. It outlines procedures for...

Aurrigo International Signs £6.28m Deal to Manufacture 25 AGVs for Ultra Global
Aurrigo International has secured a £6.28 million contract to build an initial fleet of 25 autonomous guided vehicles (AGVs) for Ultra Global, with delivery targeted for September 2027. The agreement calls for modernising existing platforms, swapping lead‑acid batteries for lithium‑ion packs, upgrading...

After Google Takeover, Intersect Spins Off Grid-Tied Power Business
Google announced a $4.75 billion cash acquisition of renewable‑energy developer Intersect, aiming to accelerate electricity generation for its expanding data‑center portfolio. Existing investors, led by TPG Rise Climate, have spun off Intersect’s grid‑tied power assets into a new independent power producer...

Efgartigimod Effective in Treating Juvenile Myasthenia Gravis
A multicenter retrospective study of 17 Chinese patients with juvenile myasthenia gravis found that weekly efgartigimod 10 mg/kg for four weeks produced rapid and substantial clinical improvement. Clinically meaningful improvement was observed in 70.6% of patients by week 1 and 91.7% by...

HELLENiQ ENERGY Launches First Solar Parks in Romania
HELLENiQ ENERGY has begun commercial operations at two photovoltaic parks in southern Romania, delivering 58 MW of capacity. The projects are part of a 2023 agreement with METLEN to develop four solar sites totaling 211 MW, with the remaining 153 MW expected online...

More Nations Commit to Nuclear Future
At the Nuclear Energy Summit in Paris, Belgium, Brazil, China and Italy joined 34 other nations in a declaration to triple global nuclear capacity by 2050. The pledge raises the coalition to 38 countries and targets 1,200 GW of nuclear generation,...

TUM RoboGym Will Begin Robot Training Midyear
Neura Robotics and the Technical University of Munich have launched the TUM RoboGym, a 2,300 m² physical AI training centre at the Munich Airport Convergence Center. The facility will host a large fleet of humanoid robots for real‑world training starting mid‑2026. Joint...

Celebrating NASA’s Mars Reconnaissance Orbiter’s 20th Anniversary: Crater Near Sirenum Fossae
NASA’s Mars Reconnaissance Orbiter celebrated its 20th anniversary by releasing a high‑resolution image of a relatively fresh impact crater near Sirenum Fossae. The crater, captured on June 3 2015, displays a sharp rim, well‑preserved ejecta and steep gullied walls that may host...

US Adds 43.2GW of New Solar PV Capacity in 2025
US solar installations fell to 43.2 GW in 2025, a 14% decline from 2024. Utility‑scale capacity led the drop, shrinking 16% to 34.7 GW, with a 40% Q4 contraction linked to safe‑harbour tax‑credit timing. Residential installs were flat, while commercial‑industrial grew 6%,...

Amazon Makes Senior Engineers the Human Filter for AI-Generated Code After a Series of Outages
Amazon has instituted a new policy requiring senior engineers to sign off on every AI‑generated code change after a string of high‑impact outages linked to generative AI tools. The internal memo from SVP Dave Treadwell cites a "trend of incidents"...

BioNTech Co-Founders Launch New mRNA Company
BioNTech announced it will create an independent biotech company dedicated to next‑generation mRNA technologies. The spin‑out will be led by co‑founders Ugur Sahin and Özlem Türeci, who will assume management by the end of 2026. BioNTech will contribute core mRNA assets in...

Camera Registries Can Support Public-Private Collaboration
City officials and private businesses are adopting camera‑registry programs to streamline video evidence collection for investigations. Registrants voluntarily share camera locations, enabling police to map assets and request footage through secure cloud portals. Coupled with digital evidence‑management platforms, agencies gain...

CSL Breaks Ground on $1.5B Illinois Immunoglobulin Plant Expansion
CSL‑Behring broke ground on a $1.5 billion expansion of its Kankakee, Illinois manufacturing complex, slated to be operational by 2031. The project will add at least 300 pharmaceutical positions and roughly 800 construction jobs, with the state offering more than $200 million...

EU Launches Clean Energy Investment Strategy
On March 10, 2026, the European Commission unveiled a Clean Energy Investment Strategy aimed at accelerating financing for Europe’s energy transition. The plan estimates a need for €660 billion of annual investment through 2030, rising to €695 billion in the following decade....

Bunnings Introducing Facial Recognition to 42 New Zealand Stores
Bunnings will deploy facial recognition technology (FRT) across its 42 New Zealand stores, beginning with a mid‑April pilot at two Hamilton locations. The rollout follows a surge in retail crime, with the retailer reporting a 9.5% rise in threatening incidents and...

Four Tricks to Make Your TV Look Like a Work of Art
Design firms Pulp Design Studios outline four methods to disguise modern televisions as artwork. Samsung’s 2017 Frame TV introduced the concept, and newer entrants like Amazon’s Ember Artline and LG’s Wallpaper TV expand the market with glare‑free, art‑focused displays. Designers...

Gemini Burrows Deeper Into Google Workspace with Revamped Document Creation and Editing
Google is embedding its Gemini generative AI deeper into Workspace, adding AI‑driven drafting and editing tools across Docs, Sheets, Slides, and Drive search. Users can prompt Gemini to create first‑draft documents, generate spreadsheets, and design slide decks while the model...

Egypt Pilots Selfie Biometrics to Streamline Access to Digital Govt Services
Egypt has launched a pilot of the MOIEG-PASS app, a selfie‑biometric platform that combines national‑ID scanning with facial recognition to authenticate users for select government services. The initiative is a joint effort by the Ministries of Interior and Communications and...

B2BMX 2026 Keynote: Elfried Samba Looks to Bring the Sexy Back to B2B Marketing
At B2BMX 2026, Elfried Samba urged marketers to treat B2B as a sexy, emotionally‑driven space rather than a purely technical one. He highlighted that human connection and community‑first strategies are the strongest growth levers, citing his agency Butterfly Effect’s work...
Antibiotic Resistance Can Vary Depending on Where the Bacteria Live
Researchers at the Technical University of Denmark discovered that antibiotic resistance measurements can shift dramatically when test conditions change. Standard laboratory assays use fixed, uniform environments, but altering factors such as growth medium or temperature can make the same bacterium...

AgentMail Raises $6M to Build an Email Service for AI Agents
AgentMail, a San Francisco startup, raised a $6 million seed round led by General Catalyst to launch an API‑driven email service built for AI agents. The platform lets agents create and manage dedicated inboxes with threading, labeling, search and reply capabilities,...

Gemini Embedding 2: Our First Natively Multimodal Embedding Model
Google DeepMind announced Gemini Embedding 2, its first natively multimodal embedding model, now in public preview via the Gemini API and Vertex AI. The model maps text, images, video, audio, and PDF documents into a unified 3,072‑dimensional space, handling up to 8,192...

HCP Vault Dedicated Now Available in Additional AWS and Azure Regions
HashiCorp announced that HCP Vault Dedicated is now available in four new cloud regions—AWS Stockholm and Paris, and Azure Australia East and Australia Central. The expansion broadens the service’s global footprint, giving customers the ability to locate Vault clusters closer...

75% of Firms Skip Regular Identity Recovery Tests: Survey
The Quest Software State of ITDR survey of 650 senior IT and security executives reveals a striking gap in disaster‑recovery hygiene. More than three‑quarters of respondents admit they do not rehearse identity‑focused recovery within the recommended six‑month window, and nearly...

Impulse Space Expands Colorado Presence
Impulse Space has opened a 20,000‑square‑foot manufacturing facility near Boulder, Colorado, dedicated to developing guidance, navigation and control (GNC) systems and precision‑machined components for its Mira and Helios transfer vehicles. The plant will scale in‑house production of valves, pumps, and...

Only 24% Of Organizations Test Identity Recovery Every Six Months
Identity and access management now underpins modern enterprises, linking users, applications, automation tools, and cloud services. Quest Software’s survey shows only 24 % of organizations test their identity disaster‑recovery plans every six months, while 24 % never test at all. Companies that...

The 3 Very Best Robot Vacuums for Pets
The Strategist’s latest guide ranks the top robot vacuums for households with pets, highlighting three models: the Roborock Q7+ Max as overall winner, the Roborock Saros 10R for combined vacuum‑mop performance, and the budget‑friendly Matic. The review is based on hands‑on...

WNBA Star Kelsey Plum Launches a Verified AI Digital Twin
WNBA star Kelsey Plum has become the first professional female athlete to launch a verified AI digital twin, partnering with Talk2Me to create a voice‑enabled avatar that fans can call. The twin mirrors Plum’s personality, allowing one‑on‑one conversations when she’s...

New York Lawmaker Wants Moratorium on Sale of AI Chatbot-Enabled Kids’ Toys
New York State Senator Andrew Gounardes is drafting a bill that would place a moratorium on the sale of AI‑enabled, chatbot‑powered toys for children. The legislation comes as AI‑infused plush toys and dolls, already popular in China, are gaining traction...

Govt Set to Launch New Version of PM KUSUM Scheme Focusing on Agri Solar PV Component
The Indian government is preparing to launch PM KUSUM 2.0, a revamped version of the 2019 renewable‑energy scheme that will add a dedicated 10 GW agri‑PV component. The original PM KUSUM aimed for 34,800 MW of solar capacity and has already installed over 10 lakh standalone...

AWS Innovator Caylent Selects New CEO To Drive Agentic AI, Customer ROI
Caylent, an AWS Premier Services partner and AI innovator, has appointed Valerie Henderson as its new CEO. Henderson, who previously served as president and CRO, aims to transform Caylent into an AI‑first, agentic delivery powerhouse. The firm plans to embed...

Consumer Anxiety Is Reshaping Retail. Technology Is the Antidote
Consumer anxiety, fueled by rising fraud and economic uncertainty, is reshaping retail behavior, according to SOTI’s global survey. Over half of U.S. shoppers have experienced fraud, and 69% say inflation and supply‑chain issues have altered their purchasing habits. Retailers must...

Nvidia Invests In AI Startup Thinking Machines
Nvidia announced a multiyear strategic partnership with AI startup Thinking Machines Lab, pledging at least one gigawatt of its Vera Rubin computing systems for frontier‑model training. The deal, led by former OpenAI CTO Mira Murati, aims to have the platform...

Lightpath Streamlines Access to Federal Agency Deals
Lightpath has secured a General Services Administration Multiple Award Schedule (MAS) contract, enabling federal agencies to procure its AI‑grade fiber infrastructure through the GSA eBuy platform. The agreement also extends to state, local, and education (SLED) agencies via cooperative purchasing,...

Anonyme Labs Partners with Utah Valley University to Introduce Student Digital Wallet
Anonyme Labs has teamed with Utah Valley University to launch a pilot digital wallet that stores student IDs and other academic credentials as verifiable credentials. The solution leverages Open Badges 3.0, OpenID4VC and DIDComm protocols, allowing cryptographically secure sharing from smartphones....

Google Deepens Gemini AI Integration Across Workspace and Introduces User Controls for AI Search in Photos
Google announced an expanded rollout of Gemini‑powered AI across its core Workspace suite, embedding generative features into Docs, Sheets, Slides, and Drive. The new “Help me create” tool drafts documents by pulling context from Gmail, Chat and Drive, while Sheets...

ARPA-H Launches Program to Develop Biosensors that Can Track Multiple Signals
The Advanced Research Projects Agency for Health (ARPA‑H) has launched the Delphi program to develop modular biosensors that can monitor multiple physiological signals such as inflammation markers, hormones, and drug levels. The initiative relies on electronic "chiplet" technology, allowing developers...

ARPA-H Launches Program to Develop Biosensors that Can Track Multiple Signals
The Advanced Research Projects Agency for Health (ARPA‑H) has unveiled the Delphi program to create modular biosensors that can monitor multiple biomarkers such as inflammation markers, hormones, and drug levels. The initiative relies on electronic "chiplet" technology, allowing developers to...

Rhoda AI Raises $450M to Build Foundational Robotics Models that Learn From Internet Videos
Palo Alto‑based Rhoda AI announced a $450 million Series A round that lifts its valuation to $1.7 billion. The startup aims to train foundational robotics models using publicly available internet videos, a method it calls Direct Video Action. By supplementing limited robot telemetry...

NASA Space Probe Expected to Reenter the Atmosphere with a Chance of Raining Debris
NASA’s Van Allen Probe A re‑entered Earth’s atmosphere on March 11, 2026, burning up over the Pacific Ocean south of Mexico. The 600‑kilogram spacecraft, launched in 2012 to study the planet’s radiation belts, came down months earlier than the projected 2034 timeline due...

Data Center Security Compliance Checklist
The March 2026 update of the Data Center Security Compliance Checklist expands the traditional security framework to include AI‑governance and sustainability mandates. It outlines cross‑team alignment, the shift to PCI DSS 4.0, and the relevance of standards such as SOC 2, ISO 27001, GDPR, FedRAMP...

Largest California Utility Could Have 3,800 Electric Fleet Vehicles By 2030
Pacific Gas and Electric (PG&E), California’s largest utility, announced a plan to electrify 3,800 of its roughly 9,700 on‑road vehicles by 2030, covering 100% of light‑duty, 50% of medium‑duty, and 20% of heavy‑duty fleets. The utility currently operates 821 EV...

Restoring Surgeons’ Sense of Touch with Robotic Fingertips
A Europe‑wide EU‑funded consortium called PALPABLE is creating a soft‑robotic fingertip that restores tactile perception for minimally invasive and robotic surgery. The device uses fibre‑optic sensors embedded in a silicone dome to translate tissue deformation into visual stiffness maps, helping...

As AI Data Centers Scale, Investigating Their Impact Becomes Its Own Beat
The generative‑AI boom is driving hyperscalers such as Microsoft, Google, Amazon and Meta to earmark over $700 billion in capital spending for new AI‑focused data centers by 2026, a 60% jump from the previous year. These facilities dwarf traditional sites, consuming...